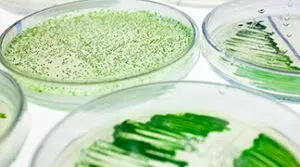

objectives
1. Develop, Implement, and distribute workforce development, education and training platforms supporting algal cultivation and algal biotechnology academic and commercial efforts.
2. Create two separate Interest Generators: Algae Academy (k-12) and Massive Open Online Courses (Algal MOOCs) through Coursera.org.
3. Establishment of Algae Cultivation Extension Short-courses (ACES) an aquaculture extension training program covering Part 1: Seaweeds and Part 2: Microalgae. ATEC Extension Program is available throughout the country, at zero charge via the Algae Foundation online platform: www.algaefoundationATEC.org
Short Course, 1-2 weeks in duration. ACES versions 2.0 to be published in 2023.
4. Collegiate Curriculum to be developed and distributed at zero costs to all ATEC member schools. In person, blended, asynchronous online, and synchronous online pedagogies adopted. Curricula centered on Algae Cultivation and Algae Biotechnology. Insertable laboratories and Intensive stand-alone lab courses are supported through a series of Image Guided Standard Operating Procedures and real time office and lab hour support.